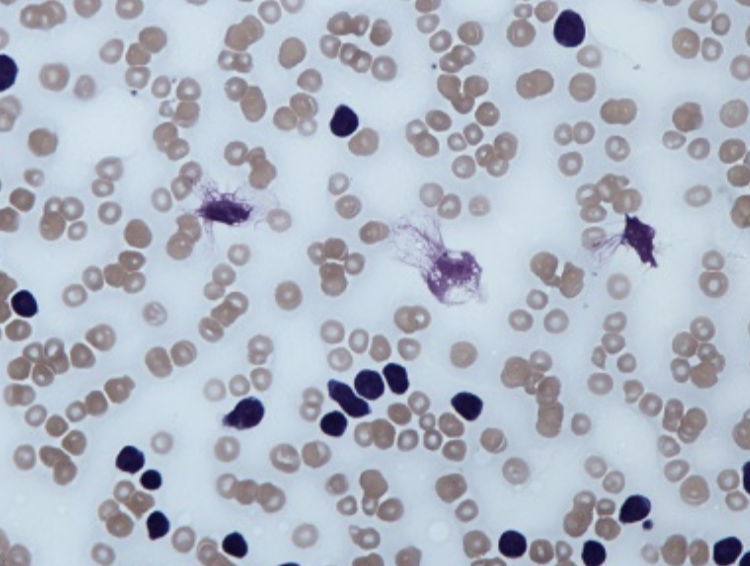
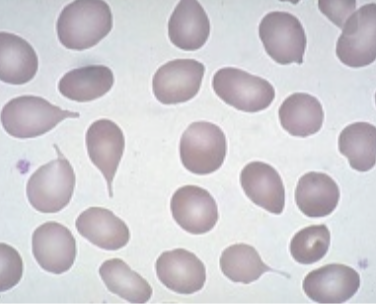

DIC:
- causes
- diagnsosis
Causes: sepsis, trauma, obstetric complications (HELLP), malignancy
Diagnosis:
- ↓ platelets
- ↓ fibrinogen
- ↑ PT & APTT
- ↑ fibrinogen degradation products
- schistocytes due to microangiopathic haemolytic anaemia
Epistaxis: management
**- Sit with torso forward and mouth open
- Pinch cartilaginous (soft) area for 20 minutes, breathe through mouth
- naseptin (chlorhexidine and neomycin) to reduce crusting and the risk of vestibulitis
- cautery if it does not stop 10-15 minutes
- packing if cautery not available
All failed: spehnopalatine ligation
Beta-thalassaemia major:
- features
- Mx
- difference with beta-thalassaemia trait
Features:
- failure to thrive in first year of life
- hepatosplenomegaly
- microcytic anaemia
- HbA2 & HbF raised, HbA absent
Mx:
transfusion + iron chelation therpay with desferrioxamine
Beta-thalassaemia trait: more non-specific anaemia and doesn’t require treatment
Haemophillia: blood tests
- prolonged APTT
- bleeding time, thrombin time, prothrombin time normal
Hyposplenism: blood film
Howell-Jolly bodies
Siderocytes
Acute lymphoblastic leukaemia:
* who does it affect?
* features
* poor prognostic factors
Acute lymphoblastic leukaemia (ALL) is the most common malignancy affecting children and accounts for 80% of childhood leukaemias.
Features:
- anaemia
- neutropenia
- thrombocytopenia: easy bruising
- hepatomegaly, splenomegaly
Poor prognostic factors:
- age < 2 years or > 10 years
- WBC > 20 * 109/l at diagnosis
- T or B cell surface markers
- non-Caucasian
- male sex
Acute myeloid leukaemia
- features
- poor prognostic factors
- acute promyelocytic leukaemia
Adult form of leukaemia
Features:
- anaemia
- neutropenia
- thrombocytopenia
- splenomegaly
- bone pain
Poor prognosis:
- > 60 years
- > 20% blasts after first course of chemo
- cytogenetics: deletions of chromosome 5 or 7
Acute promyelocytic leukaemia M3
- associated with t(15;17)
- fusion of PML and RAR-alpha genes
- presents younger than other types of AML (average = 25 years old)
- Auer rods (seen with myeloperoxidase stain)
- DIC or thrombocytopenia often at presentation
- good prognosis
Chronic lymphocytic leukaemia:
features
investigations
complications
Features: often none, incidental
Investigations:
- FBC: lymphocytosis, anaemia, thrombocytopenia
- smear: smudge cells (see pic)
Main complication: Richters transformation into a fast growing non-Hodgkin lymphoma
Chronic myeloid leukaemia:
- presentation
- management
Presentation:
- anaemia
- weight loss & sweating
- splenomegaly
Investigation:
- neutrophilia
- increased granulocytes at different stages of maturation +/- thrombocytosis
Management
- imatinib
- hydroxyurea
- interferon-alpha
- allergic bone marrow transplant
Burkitts lymphoma
- cell type & association
- diagnosis
- management
- complication of management
B cell neoplasm which is associated with EBV
Diagnosis:
- microscopy: ‘starry sky’ appearance
Management: chemotherapy
Complication: tumour lysis syndrome
Rasburicase given before chemo to reduce chance of TLS!!
Hodgkins lymphoma:
- histological classification
- presentation
- investigation
- staging and management
Histology - see table
Presentation:
- lymphadenopathy (worsens with alcohol)
- assymetrical spreading lymphadenopathy
- B Sx: weight loss, night sweats
Investigation:
- normocytic anaemia
- eosinophillia
- LDH raised
- Reed-Sternberg cells
Ann-Arbor Staging:
I: single lymph node
II: 2 or more lymph nodes/regions on the same side of the diaphragm
III: nodes on both sides of the diaphragm
IV: spread beyond lymph nodes
Management: chemo

Myelofibrosis
- what is it?
- Sx
- lab findings
Scarring of bone marrow makes it more difficult for RBCs to be produced
Sx: elderly person with anaemia, massive splenomegaly and other generic Sx like weight loss & night sweats
Lab findings:
- anaemia
- ‘tear drop’ poikilocytes
- high urate and LDH
Thrombocytosis:
- what is it?
- causes
- features
- management
Thrombocytosis is an abnormally high platelet count, usually > 400 * 109/l.
Causes:
- reactive e.g. infection, post-op
- malignancy
- essential
- hyposplenism
Essential features:
- platelet count > 600 * 109/l
- both thrombosis (venous or arterial) and haemorrhage can be seen
- burning sensation in the hands
- a JAK2 mutation is found in around 50% of patients
Management:
- hydroxyurea (hydroxycarbamide) is widely used to reduce the platelet count
- interferon-α is also used in younger patients
- low-dose aspirin may be used to reduce the thrombotic risk
Polycythaemia rubra vera
- what is it?
- features
- management
Increase number of red blood cells
Features:
- pruitus
- splenomegaly
- HTN and hyperviscosity (thrombi)
- haemorrhage
- low ESR
Management:
- aspirin (reduce thrombi)
- venesecion
- chemotherapy with hydroxyurea
Sickle cell anaemia:
- crises
- management
Thrombotic: painful crisis
- prevent with hydroxyurea
Acute chest syndrome: pain relief, resp support and ABX
Aplastic crises: parovirus
Sequestration crises: pooling of blood in lungs or spleen
Requires the pneumococcal vaccine every 5 years.
Transfusion-related complications:
- non-haemolytic febrile reaction
- minor allergic reaction
- anaphylaxis
- acute haemolytic reaction
- TACO
- TRALI
non-haemolytic febrile reaction:
- fever, chills
- stop or slow transfusion, paracetamol & monitor
minor allergic reaction:
- pruitus, urticaria
- temporarily stop transfusion, antihistamine, monitor
anaphylaxis:
- hypotensions, dyspnoea, wheeze, angioedema
- stop transfusion, IM adrenaline, ABC
acute haemolytic reaction:
- fever, abdo pain, hypotension
- stop transfusion, confirm diagnosis, supportive care
TACO
- pul oedema, HTN
- slow/stop transfusion, consider loop diuretic (furosemide) and O2
TRALI:
- hypoxia, pul infiltrates on CXR, hypotension
- stop transfusion, O2 and supportive
Warfarin management
1. major bleeding
2. INR>8.0 minor bleeding
3. INR>8.0 no bleeding
4. INR 5.0-8.0 minor bleeding
5. INR 5.0-8.0 no bleeding
major bleeding
- stop warfarin
- give vit K and prothrombin complex concentrate (FFP if not available)
INR>8.0 minor bleeding
- stop warfarin
- give IV vit K and repeat after 24h if still high
- restart warfarin when INR <5.0
INR>8.0 no bleeding
- stop warfarin
- vit K orally, repeat after 24h if INR still high
- restart <5.0
INR 5.0-8.0 minor bleeding
- Stop warfarin
- Give intravenous vitamin K 1-3mg
- Restart when INR < 5.0
INR 5.0-8.0 no bleeding
- withold 1 or 2 doses of warfarin
- reduce subsequent maintenance
DOACs: MOA, excretion, reversal
- dabigatran
- rivaroxaban
- apixaban
- edoxaban



